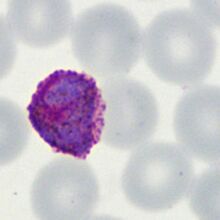

Macro & micro gametocytes PO
From MalariaETC
| Navigation |
| >Previous Page |
| Macrogametocytes and microgametocytes
Macro and micro-gametocytes with "Rod-shaped" form (P.falciparum). P.falciparum: The "rod shaped" parasites of P.falciparum are a little different for the two parasite forms: the length of the parasites differ with the left parasite being noticeably longer, this means that the red cell membrane affects the two parasite forms differently - the macrogametocyte (left) is restricted and curved by the ghost red cell membrane (that now appears as an empty "blister" on the side of the erythrocyte; the microgametocyte (right) does not fll the ghost erythrocyte and so the parasite is straight with "floppy" membrane to each side.
P.vivax: The large irregular/round macrogametocyte (left) of these two species tend to be much larger than the surrounding normal red cells. In the examples shown (P.vivax), the parasite is constrained within an enlarged red cell with almost no visible membrane. By contrast the microgametocyte (right) can be seen to be much smaller by comparison with the normal red cells and which does not fully fill the red cell, with residual membrane visible around the parasite. Very similar appearances may be seen in P.ovale although the size of parasites is generally less and species-specific features may differ slightly.
P.malariae: The small round macrogametocyte (left) of this species tend to have normal or reduced size compared with non-infected red cells. In the examples shown (P.malariae), the parasite is contained within a red cell of reduced size but neither the macrogametocyte nor microgametocyte fills the red cell. |